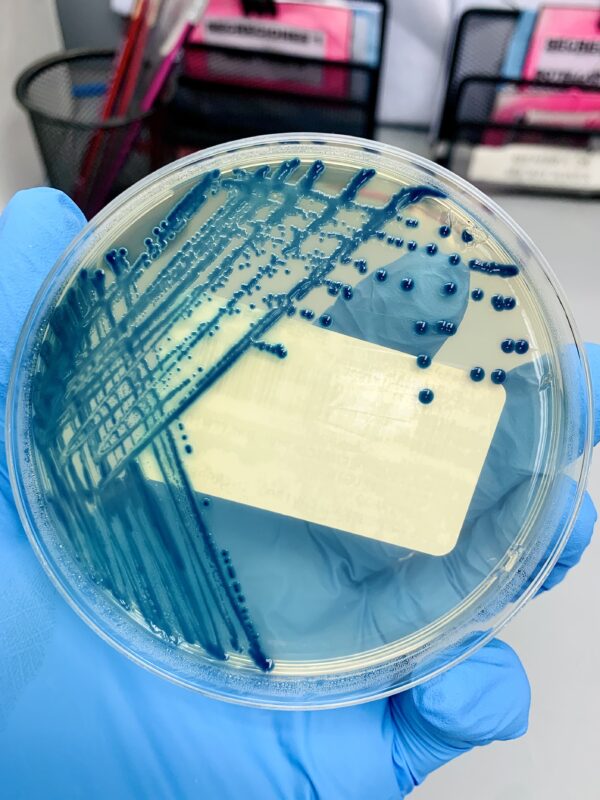

Title: AZUL MORTAL
Votes: ?
Category: Investigación Científica y Tecnológica
Views: ?
Description: El agar cromogénico muestra el espectáculo de pasar de lo invisible a lo visible, colonias bacterianas de color azul intenso indicando BLEE positivo. BLEE, Betalactamasas de Espectro Extendido son enzimas bacterianas que confieren resistencia a antibióticos betalactámicos lo que pone en riesgo a las personas por tener menos fármacos disponibles para tratar las infecciones. Entre los años 2010 y 2011 lo hermoso del azul se convierte en una pesadilla que sacudió los hospitales de la ciudad de Panamá; porque las bacterias resistentes a los antibióticos acabaron con la vida de muchos pacientes. Es ahí donde el laboratorio clínico con experticia detecta lo que se escapa a simple vista: resistencias. Estudiar el comportamiento de estas bacterias ayuda a los científicos a buscar nuevos fármacos o métodos alternativos de tratamiento, además, su investigación contribuye de forma positiva al sistema de vigilancia global de la OMS contribuyendo con su base de datos. La resistencia a los antimicrobianos (RAM) está siendo considerada por expertos internacionales como la próxima pandemia silenciosa, una amenaza actual que requiere atención.